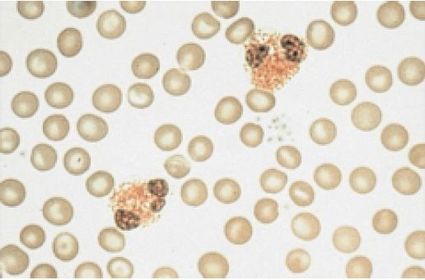
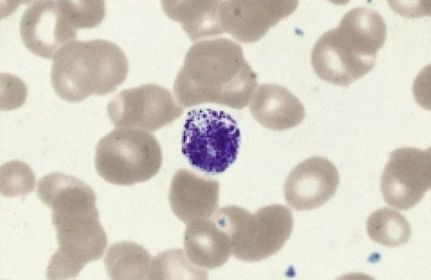
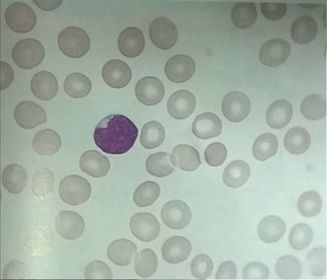
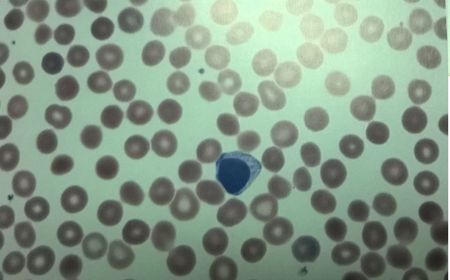
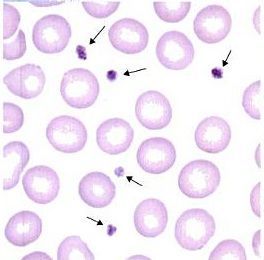
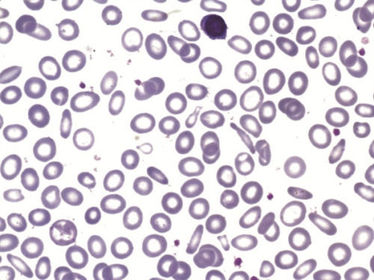
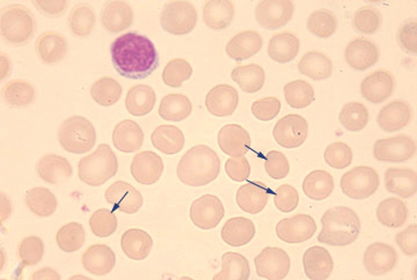
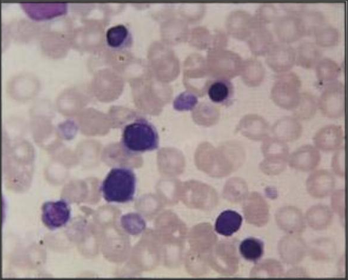
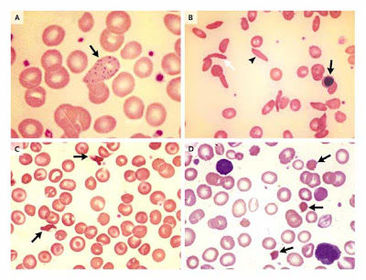

Recopilación de células sanguíneas según su linaje.
|
|
Criado por myslandeo_iop
mais de 10 anos atrás
|
|

Tirsa Pamela Chávez Vásquez
201315395

Glóbulos rojos
(Eritrocitos o hematíes)
Figura 1 Eritrocitos maduros en frote de sangre periférica
(García & Sastre, 2013).

Célula troncal
(stem cell)
Figura 2 Esquema de la célula troncal
(NIH, 2014).

Eritropoyesis
Factor estimulador: eritropoyetina.
Linaje: Mieloide
Proeritroblasto
Figura 4 De izquierda a derecha: frote de sangre periférica, esquema y microfotografía electrónica del proeritroblasto
(Carr & Rodak, 2010).

Eritroblasto basófilo
Figura 5 De izquierda a derecha: frote de sangre periférica, esquema y microfotografía electrónica de eritroblasto básofilo.
(Carr & Rodak, 2010)

Eritroblasto policromático
Figura 6 De izquierda a derecha: frote de sangre periférica, esquema y microfotografía electrónica de eritroblasto policromático
(Carr & Rodak, 2010)

Eritroblasto ortocromático
Figura 7 De izquierda a derecha: frote de sangre periférica, esquema y microfotografía electrónica de eritroblasto ortocrómatico
(Carr & Rodak, 2010)

Reticulocito
Figura 8 De izquierda a derecha: frote de sangre periférica y microfotografía electrónica de barrido de reticulocito.
(Carr & Rodak, 2010)

Hematié
Figura 9 De izquierda a derecha: frote de sangre periférica y microfotografía electrónica de barrido de eritrocito.
(Carr & Rodak, 2010)

Leucopoyesis
Proceso de diferenciación y maduración de los globulos blancos
Mieloblasto
Figura 11 De izquierda a derecha: mieloblasto en sangre periferica y esquema de mieloblasto
(Carr & Rodak, 2010).

Promielocito
Figura 12 De izquierda a derecha: promielocito en en médula ósea y esquema de promielocito
(Carr & Rodak, 2010).

Mielocito
Figura 13 De izquierda a derecha: mielocito en médula ósea y fotografía electrónica de mielocito
(Carr & Rodak, 2010).

Metamielocito
Figura 14 Del lado izquierdo es un metamielocito en microscopía óptica y del lado derecho en microscopía electrónica
(Carr & Rodak, 2010).

Banda
Figura 15 Banda en microscopía óptica, lado izquierdo, y electrónica, lado derecho.
(Carr & Rodak, 2010).

Neutrofilo segmentado
Figura 16 Neutrofilo segmentado en frote de sangre periférica
(Tkachuk, Hirschmann, & McArthur, 2006)

Eosinófilo
Figura 17 Eosinófilo en frote de sangre periférica
(Tkachuk, Hirschmann, & McArthur, 2006)
Basófilo
Figura 18
Basófilo en frote de sangre periférica
(Tkachuk, Hirschmann, & McArthur, 2006)
Monoblasto
Figura 19 Del lado izquierdo: Monoblasto en microscopía óptica. Derecho: esquema de monoblasto
(Carr & Rodak, 2010).

Promonocito
Figura 20 Promonocito por microscopía óptica
(Jack, 2013)

Monocito
Figura 21 Del lado izquierdo es una fotografía electrónica de monocito y del derecho es microscopía óptica
(Carr & Rodak, 2010).

Linfoblasto
Figura 22 Linfoblasto por microscopía óptica
(Conosco, 2014).

Prolinfocito
Figura 23 Prolinfocito por microscopía óptica
(Carr & Rodak, 2010).
Linfocito grande
Figura 25
Linfocito grande por microscopía óptica
(Carr & Rodak, 2010).
Linfocito pequeño
Figura 26 Linfocito pequeño por microscopía óptica
(Conosco, 2014).

Megacarioblasto
Figura 26 Megacarioblasto por microscopía óptica
(Carr & Rodak, 2010).

Promegacariocito
Figura 27 Promegacariocito por microscopía óptica
(Carr & Rodak, 2010).

Megacariocito
Figura 28 Superior megacariocito estadio temprano médula ósea Inferior esquema de megacariocito
(Carr & Rodak, 2010).

Plaquetas
Figura 29 Plaquetas señalas por una flecha
(Carr & Rodak, 2010).
ANEMIAS
Anemia microcítica hipocrómica
Fígura 31 Frote periférico que muestra hipocromía, microcitosis, células blanco y eliptocitosis
(Sans, 2014).
Anemia Normocítica Normocrómico
Figura 32 Frote periférico con esferocitosis (San, 2013).
Anemia Macrocítica no megaloblástica
Figura 33 Frote periférico con macrocitosis
(Telmeds, 2009).

Anemia macrocítica megalobástica
Figura 34 Frote de médula ósea con megaloblastos
(Palma, 2010).

Anemia Hemolítica
Figura 35 Frote de sangre periférica anemia hemolítica extracorpuscular
(Manascerco, 2003).
Anemia de células falciformes
Figura 36 Frote de sangre periférica con células falciformes
(Passarge, 2010).

Talasemia
Figura 37 Frote periférico con poiquilocitosis
(Gaffera, 2009).
Leucemia Linfoide Aguda
Figura 38 Frote periférico con linfoblastos (LLS, 2013).

Leucemia Mieloide Aguda
Figura 39 Frote se sangre periférica con mieloblastos
(Krugman & Jones, 2013).

Leucemia linfoide crónica
Figura 40 Frote de sangre periférica con linfocitosis (DMCA, 2010).

Leucemia mieloide crónica
Figura 41 Cromosoma Filadelfia
(INC, 2015).

Referencias Bibliográficas
Carr, J.H., & Rodak, F.B. (2010). Atlas de hematología clínica (3a ed.). Buenos Aires: Médica Panamericana.
Ciesla, B. (2014). Hematología en la práctica (2 ed.). (C. Falla, Trad.) Venezuela: AMOLCA.
Conosco, F. (2014). Atlas de hematología. Obtenido de https://hematologia.farmacia.ufg.br/p/7067-linfoblasto
INC. (2015). Leucemia mielógena crónica: tratamiento. Recuperado de http://www.cancer.gov/espanol/tipos/leucemia/paciente/tratamiento-lmc-pdq
Jack, S. (2013). Diary of medical scientist. Obtenido de fyeahmedlab.tumblr.com/post/38887700918/clinical-lab-scientist-promonocyte-clearly
Krugman, T., & Jones, M. (2013). Leucemia mielógena aguda. Recuperado de http://ec.ofsen.com/la-leucemia-mielogena-aguda-lma
McKenzie, S.B. (2010). Hematología clínica (4a ed.). México: Manual Moderno.
NIH. (2014). Célula madre hematopoyética. Recuperado de http://www.cancer.gov/espanol/publicaciones/diccionario?cdrid=693540
Ortíz, B. (2013). Hematopoyesis. Recuperado de http://image.slidesharecdn.com/hematopoyesis-130403222540-phpapp02/95/hematopoyesis-2-638.jpg?cb=1365027975
San, L. (2013). StudyDroid. Recuperado de http://www.studydroid.com/index.php?page=viewProfile&userId=49438
Sans, L. (2014). Diary of a medical scientist. Recuperado de http://fyeahmedlab.tumblr.com/post/66955008258/thwapology-iron-deficiency-anemia-an-example
Telmeds. (2009). Macrocitosis. Recuperado de http://www.telmeds.org/wp-content/uploads/2009/05/macrocitosis1.jpg

 Ocultar acertos
Ocultar acertos
